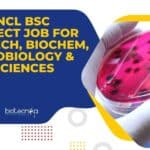
CSIR-NCL BSc Project Job For Biotech, Biochem, Microbiology & Life Sciences NCL BSc Project Job
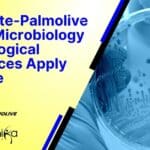
Colgate-Palmolive Job, Microbiology & Biological Sciences Apply Online Colgate-Palmolive Job

Home Search
biology - search results
If you're not happy with the results, please do another search
NCL MSc & BTech Biotech, Biochem, Microbiology Project Job Opening
CSIR-NCL Job Opening For MSc & BTech Biotech, Biochem, Microbiology
CSIR-NCL Job Opening For MSc & BTech Biotech, Biochem, Microbiology. NCL Pune is hiring BTech...
CSIR-NCL BSc Project Job For Biotech, Biochem, Microbiology & Life Sciences
NCL BSc Project Job Opening For Biotech, Biochem, Life Sciences
NCL BSc Project Job Opening For Biotech, Biochem, Life Sciences. NCL Pune is hiring BSc...
CFTRI Biotech, Biochem, Life Sciences, Microbiology Project Associate Recruitment
CFTRI Associate Job Opening For MSc Candidates - Apply Online
CFTRI Associate Job Opening For MSc Candidates - Apply Online. CSIR-CFTRI Job Opening. MSc Biotechnology/...
Sartorius BTech & MSc Biotech, Microbiology Job – Minimum 0-2 Years Exp Apply
Sartorius Lab Tech Jobs - MSc & BTech Apply Online
Sartorius Lab Tech Jobs - MSc & BTech Apply Online. Exclusive job opportunities for microbiology,...
SACON Zoology & Wildlife Biology Job Openings – Apply Online
SACON Biologists Jobs 2022 - Online Application Process
SACON Biologists Jobs 2022 - Online Application Process. MSc Wildlife Biology/ Zoology Field Biologist vacancies at SACON....
20+ Govt HSSC Jobs 2022 For MSc Biochem, Microbiology, Botany, Zoology, Biology
HSSC Jobs 2022 - Scientific Assistant Job Openings
HSSC Jobs 2022 - Scientific Assistant Job Openings. Haryana Staff Selection Commission Jobs. Biochem, Microbiology, Botany, Zoology,...
Colgate-Palmolive Job, Microbiology & Biological Sciences Apply Online
Colgate-Palmolive Job, Microbiology & Biological Sciences Apply Online
Colgate-Palmolive Job, Microbiology & Biological Sciences Apply Online. MSc Biological Sciences & Microbiology Jobs. Interested and eligible...
CSIR-IGIB Biotech, Biochem, Immunology, Life Sciences & Microbiology Project Jobs
IGIB Research Vacancies 2022 For Life Sciences, Biotech - Apply Online
IGIB Research Vacancies 2022 For Life Sciences, Biotech - Apply Online. IGIB Research Openings...
Freshers Project Intern Jobs For BSc Biotech & Microbiology at ICT Mumbai
Freshers Project Intern Jobs For BSc Biotech & Microbiology at ICT Mumbai
Freshers Project Intern Jobs For BSc Biotech & Microbiology at ICT Mumbai. BSc...
Cipla Cell Biology Analyst Job – MSc Biotech & Life Sciences Apply
Cipla Cell Biology Job Opening - Biotech & Life Sciences Apply
Cipla Cell Biology Job Opening - Biotech & Life Sciences Apply. MSc Biotech &...
BNHS Research Fellow Job For MSc & PhD Life Sciences, Zoology & Wildlife Biology
BNHS Research Fellow Job For MSc & PhD Life Sciences, Zoology & Wildlife Biology
BNHS Research Fellow Job For MSc & PhD Life Sciences, Zoology...
Project Assistant Job Opening at RGCB For Biotech, Biochem & Biology
Project Assistant Job Opening at RGCB For Biotech, Biochem & Biology
Project Assistant Job Opening at RGCB For Biotech, Biochem & Biology. Rajiv Gandhi Centre...
Cepheid QC Analyst Job Opening For MSc Biochem, Mol Bio, Microbiology
Cepheid QC Analyst For Mol Bio, Microbiology & Biochem, Apply Online
Cepheid QC Analyst For Mol Bio, Microbiology & Biochem, Apply Online. MSc Biochemistry, Molecular...
Freshers Welcome to Apply Online at Charles River – MSc Biotech, Biochem, Biology, Life...
Charles River Freshers Jobs - Life Sciences Apply Online
Charles River Freshers Jobs - Life Sciences Apply Online. MSc Biotech, Biochem, Biology, Life Sciences &...
Vallabhbhai Patel Chest Institute University of Delhi Life Sciences, Biotech & Microbiology Jobs
VPCI University of Delhi Life Sciences, Biotech & Microbiology Jobs
VPCI University of Delhi Life Sciences, Biotech & Microbiology Jobs. Vallabhbhai Patel Chest Institute Delhi...